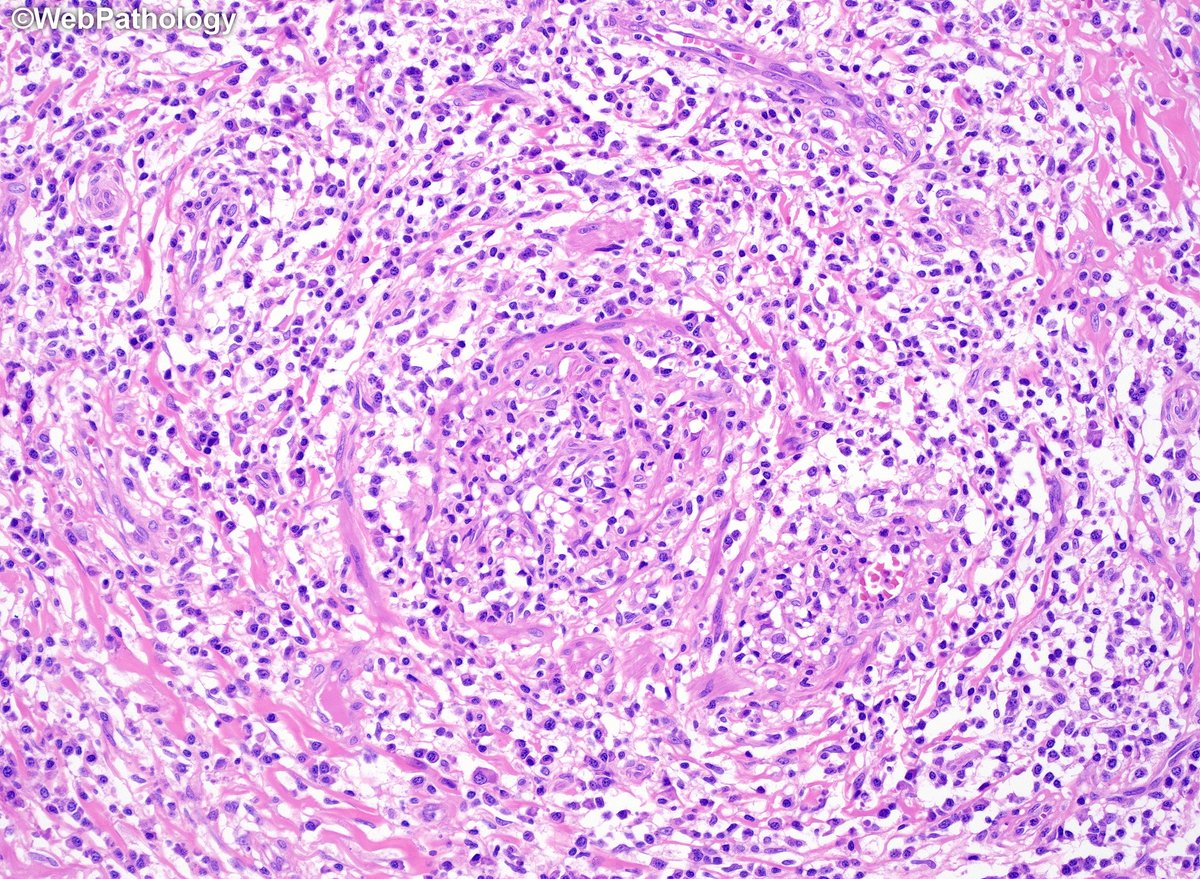
WebPathology's tweet image. Adult male with a large ulcerated and indurated lesion on foreskin. What would you do next? Additional images and diagnosis will be posted later. #gupath

RigelGar
@RigelGar
Gracias a Dios mamá. Mexicana orgullosa. Patóloga en formación siempre. Música y escritora si volviera a nacer.
Dit vind je misschien leuk
📷 NGC 3324, Keyhole Nebula tmblr.co/ZLB4bw2XFKRk4

Algoritmo de Manejo de la Hipertensión según las Guías Europeas 2024 👇 #ESC #Cardiologia #MIR #ENARM #2MIR25

Adult male with a large ulcerated and indurated lesion on foreskin. What would you do next? Additional images and diagnosis will be posted later. #gupath

Join GlomCon this Sunday Evolution of the KDIGO Guidelines by Dr. Brad Rovin and Dr. Sayna Norouzi ID: 817 4374 4653 Passcode: 202122 Sign up 👉 bit.ly/signup-glomcon #GlomCon

La Luna tiene un lado que nunca vemos desde la Tierra. Muy pronto, la tripulación de @NASAArtemis II explorará este lado lejano durante un sobrevuelo. La información que recolecten será fundamental para futuras misiones: go.nasa.gov/49VCFK0

(11/n) @RutaGupta and colleagues provide helpful tips to navigate challenges in head and neck pathology in a special issue of @Human_Pathology.

The Southeast Asian Urological Pathology Society (SEAUPS) proudly presents: ugm-id.zoom.us/meeting/regist…

Skeletal muscle tumors - malignant (basic facts for residents)

Casi todo mi conocimiento actualizado se lo debo a una informática kazaja que consideró que la información científica era de uso público y debía estar a nuestra disposición gratuitamente:

The art of grossing. A 29 yo man with right testicular pain. Radical Orchiectomy + Partial Scrotectomy. 7.6x5.4cm tumor. Final Diagnosis. Viable Tumor: Yolk Sac Tumor (20%)+ Embryonal Carcinoma (10%) + Extensive Necrosis (70%). #pathology #pathresidents #GUpath @pathTweeter

📙Carta del editor #AnalesdeQuímica Benceno: la molécula que abrió la puerta a un universo de carbono aromático 🧑🔬Nazario Martín León. Departamento de Química Orgánica, @unicomplutense @IMDEA_Nano ➡️shre.ink/5Odz

I just updated my notes on "Soft tissue tumors" for my teaching website, "Kurt's Notes" (kurtsnotes.net). 🔬🔬🔬🔬🔬🔬🔬🔬🔬🔬🔬🔬🔬🔬🔬🔬🔬🔬🔬🔬🔬🔬🔬🔬🔬🔬🔬🔬🔬🔬 Full notes available here: schaberg.faculty.ucdavis.edu/wp-content/upl…




New in #HumPathol: Making Routine Head and Neck Pathology Easy: From Dissection to Diagnosis. sciencedirect.com/science/articl… #pathology #PathTwitter #PathX #ENTpath

2. Autovalidación > validación social La mayoría de la gente publica para conseguir "me gusta". No lo necesitan. Su autoestima no se obtiene mediante el crowdsourcing. Dependen de la alineación interna, no de la aprobación externa. Eso es confianza silenciosa, no inseguridad.

Histopathological featurs of CHRONICITY in colon biopsy #GIpath #PathX #Pathology

Before you go on your well-deserved holidays, pre-register for our next #IACwebinar 22nd Jan 2026 at 14:00 CET: Updates in Pediatric Thyroid Cytology by Prof. Vivian Weiss, MD cytology-iac.org/educational-re…

I woul like to share with you next information:

Here's a little nudge for all #IACmembers. Register for this #IACwebinar on 18th Dec at 14:00 CET: Morphologic Clues & Ancillary Studies to Accurately Diagnose Lung Tumors. Our host: Prof. Peter B. Illei cytology-iac.org/educational-re…

United States Trends
- 1. Paddy N/A
- 2. #UFC324 N/A
- 3. Alex Pretti N/A
- 4. Learner Tien N/A
- 5. Ilia N/A
- 6. Arman N/A
- 7. Moro N/A
- 8. #LingOrmHKFanmeetD2 N/A
- 9. LINGORM HONGKONG MEET N/A
- 10. O'Malley N/A
- 11. Beerus N/A
- 12. Muratalla N/A
- 13. Medvedev N/A
- 14. Kyle Rittenhouse N/A
- 15. Dragon Ball N/A
- 16. Derrick Lewis N/A
- 17. #Toonami N/A
- 18. Suga N/A
- 19. WHAT A FIGHT N/A
- 20. #SNME N/A
Something went wrong.
Something went wrong.




























































































































